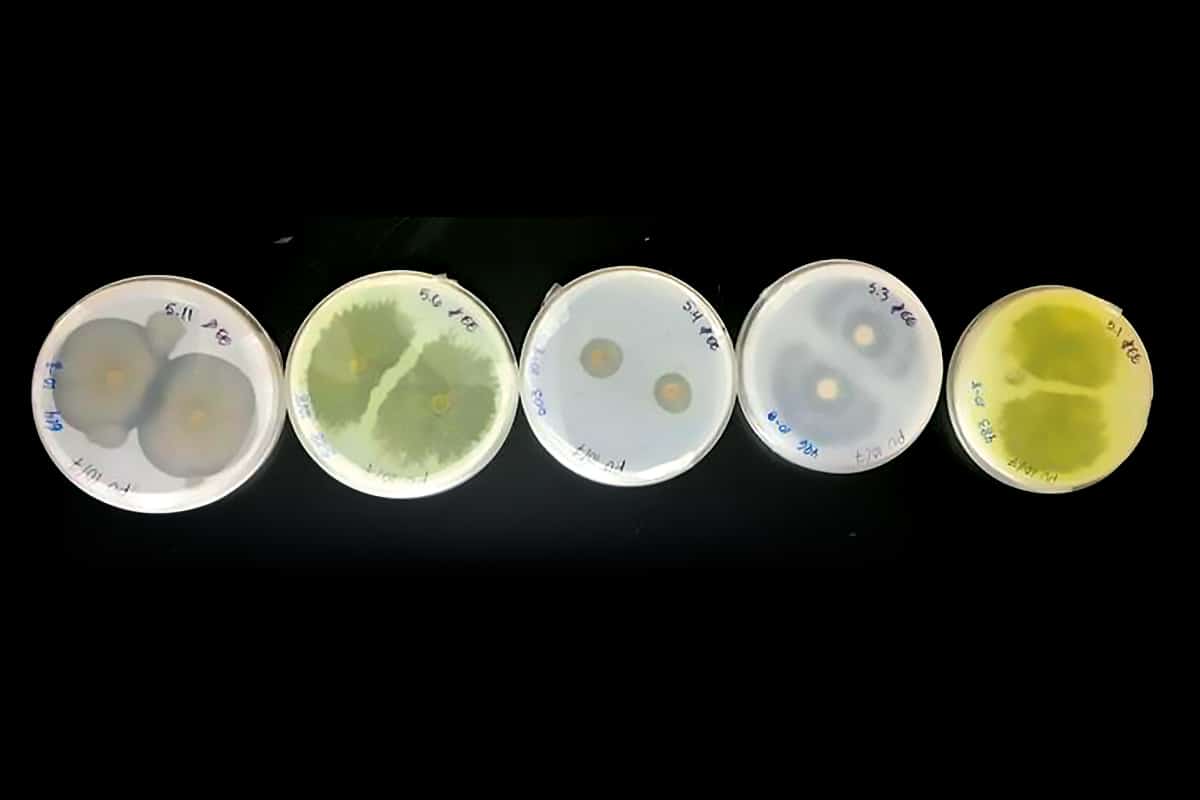

Champignons marins isolés à Hawaï : les halos translucides correspondent à la dégradation du plastique. Photo: Ronja Steinbach, Université d’Hawaï
Des champignons marins pourraient aider les scientifiques à se débarrasser des déchets en plastique.
Le plastique représente au moins 85 % des déchets marins. Non seulement ce matériau contient des substances nocives pour les écosystèmes, mais, au lieu de se décomposer, il se fragmente en minuscules particules nuisibles à la faune. À Hawaï, une équipe a découvert de surprenants alliés contre cette pollution. Récoltés sur le littoral de ces îles du Pacifique, sur le sable, les coraux et les algues, des champignons marins se sont montrés capables de décomposer du plastique. Certaines espèces peuvent même être conditionnées à en dévorer encore plus rapidement.
« Les champignons marins constituent un groupe largement sous-étudié. Or, ils présentent une activité enzymatique élevée, ce qui en fait des candidats prometteurs pour la dégradation des plastiques », dit Ronja Steinbach, étudiante en biologie marine au Collège des sciences naturelles de l’Université d’Hawaï, à Mānoa. Elle signe l’étude parue dans Mycologia avec la doctorante Syrena Whitner et le professeur Anthony Amend.
Pour ces travaux, l’équipe a ajouté du polyuréthane, un plastique commun utilisé dans les mousses et autres matériaux flexibles, dans des boîtes de Petri à l’intérieur desquelles étaient cultivées différentes souches de champignons. Sur les 68 souches testées, 42 ont démontré une capacité à décomposer le plastique !







